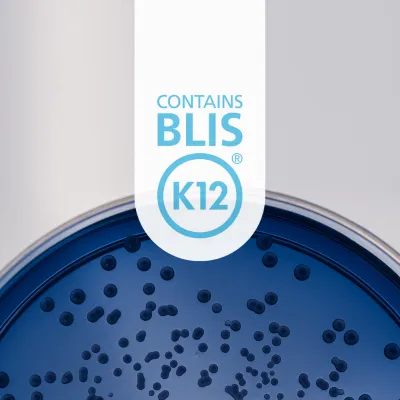
BLIS K12™ Oral Probiotic Ingredient

BLIS K12™ Oral Probiotic Ingredient
Exhibitor Products
Information
BLIS K12™ is specific strain of Streptococcus salivarius, a beneficial species native to the oral microbiota.
A multi-faceted probiotic that is proven to protect against both viral and bacterial threats, BLIS K12™ delivers targeted support to oral and systemic health, making it a standout solution for maintaining a healthy oral microbiome and immune system.
Link to product
Ingredient: Specialty
Probiotics